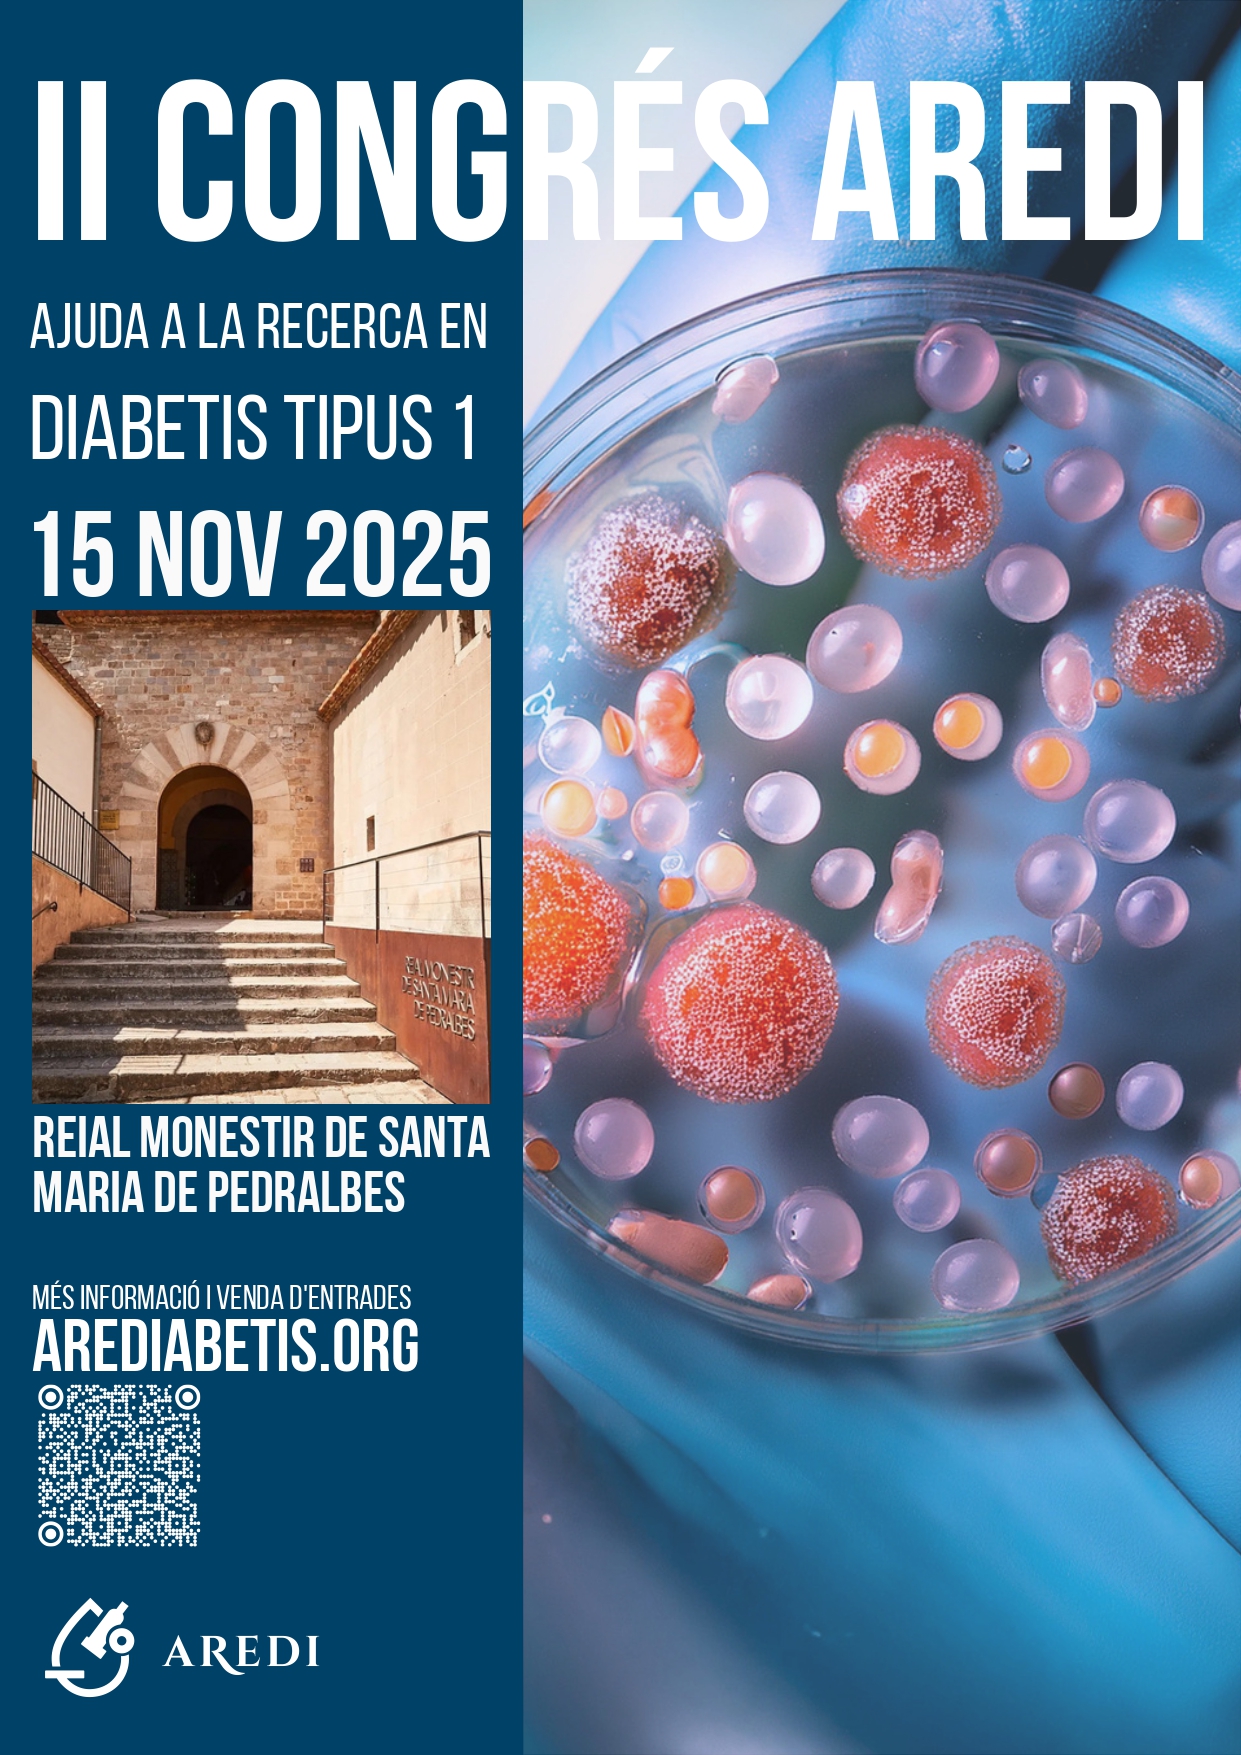

Data inici *
Districte *
Les Corts
II Congrés AREDI al Monestir de Pedralbes
Un matí únic dedicat a la divulgació científica, la recerca de qualitat i la solidaritat en diabetis.
Ponències de primer nivell amb especialistes en diabetis tipus 1
Testimonis reals que posaran veu a l’experiència quotidiana amb la malaltia.
Presentació de projectes científics impulsats per AREDI
Un ambient acollidor, rigorós i humà per aprendre i sumar esforços